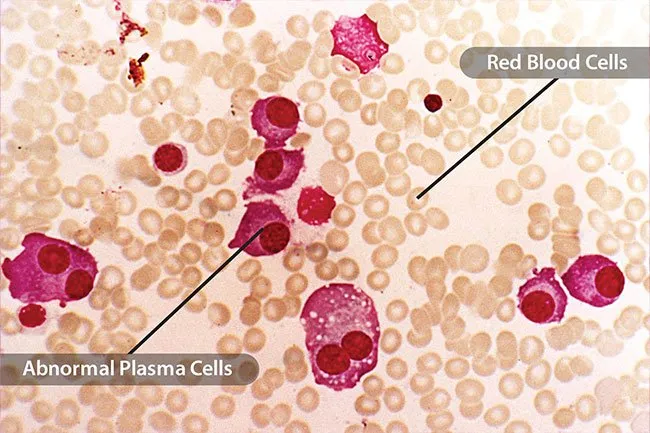
多發(fā)性骨髓瘤 多發(fā)性骨髓瘤

影響腎臟的疾病種類繁多,主要包括以下幾類:
腎臟健康:影響腎臟的疾病有哪些?
慢性腎病 (CKD)

當(dāng)健康問(wèn)題影響到腎臟時(shí),它們會(huì)導(dǎo)致慢性腎什么是慢性腎病-原因-癥狀有哪些?臟病 (CKD)。這是一種永久性損傷,可能會(huì)隨著時(shí)間的推移而惡化。如果腎臟受損嚴(yán)重,無(wú)法正常工作,則稱為腎衰竭或終末期腎病 (ESRD)。治療通常是透析(由機(jī)器完成腎臟的正常工作)或移植(從捐贈(zèng)者那里獲得一個(gè)新的健康腎臟)。
糖尿病
這種導(dǎo)致腎衰竭的主要原因會(huì)損害器官的小血管和過(guò)濾器。這使得它們很難凈化血液。你的身體會(huì)保留比應(yīng)有的更多的鹽和水,你的系統(tǒng)中會(huì)有更多的廢物。這種疾病造成的神經(jīng)損傷會(huì)使尿液回流,并通過(guò)壓力或感染損害你的腎臟。

神經(jīng)性厭食癥
患有此病的人對(duì)身體形象不切實(shí)際,而且他們吃的量不足以保持健康體重。(他們的體重至少比正常體重低 15%)。這會(huì)導(dǎo)致體內(nèi)缺水、電解質(zhì)和鹽,從而導(dǎo)致慢性腎病,最終導(dǎo)致腎衰竭。對(duì)于那些暴飲暴食并通過(guò)催吐(嘔吐或使用瀉藥)來(lái)消耗熱量的人來(lái)說(shuō),情況尤其如此。

高血壓
如果流經(jīng)您身體的血液壓力過(guò)高,您的血管(包括腎臟中的血管)就會(huì)被拉伸、留下疤痕,甚至變得脆弱。這會(huì)阻止它們正常地排出廢物,而血管中的多余液體會(huì)進(jìn)一步升高您的血壓,從而導(dǎo)致危險(xiǎn)的循環(huán)。可以通過(guò)藥物治療以及改變飲食、運(yùn)動(dòng)習(xí)慣和壓力水平等來(lái)治療。

高膽固醇
如果你體內(nèi)有太多的壞膽固醇,它會(huì)在輸送血液進(jìn)出腎臟的血管中堆積,從而影響腎臟的功能。它還會(huì)使你更容易患高血壓和糖尿病。血液測(cè)試可以告訴你你的膽固醇水平是否過(guò)高。

狼瘡
這是一種使免疫系統(tǒng)攻擊身體某些部位的疾病。當(dāng)它影響腎臟時(shí),就稱為狼瘡性腎炎。它會(huì)導(dǎo)致腎臟中過(guò)濾廢物的小血管發(fā)炎和結(jié)疤,有時(shí)也會(huì)影響腎臟。可以用不同的藥物治療:有些會(huì)影響免疫系統(tǒng),而有些則有助于控制血壓或消除腫脹和多余液體。

多發(fā)性骨髓瘤
這種癌癥與幫助您抵抗感染的白細(xì)胞(血漿)有關(guān)。癌細(xì)胞在骨髓中積聚,在那里它們排擠健康的血細(xì)胞并產(chǎn)生可能導(dǎo)致腎臟問(wèn)題的異常蛋白質(zhì)。超過(guò)一半的多發(fā)性骨髓瘤患者最終也會(huì)出現(xiàn)腎臟問(wèn)題。
溶血尿毒癥綜合征
當(dāng)腎臟和其他器官的小血管受損時(shí),就會(huì)發(fā)生這種情況。這最終會(huì)導(dǎo)致腎衰竭。這種情況發(fā)生在腹瀉 5 到 10 天后,通常由感染引起,例如大腸桿菌或某些藥物。如果及時(shí)治療,大多數(shù)人都會(huì)康復(fù)。如果您腹瀉數(shù)天,小便不頻繁,并且非常疲倦,請(qǐng)去看醫(yī)生。您還可能會(huì)出現(xiàn)瘀傷或異常出血。

ANCA血管炎
此時(shí),您自身的抗體(通常用于抵抗細(xì)菌)會(huì)攻擊腎臟和其他器官中的小血管。這可能會(huì)導(dǎo)致尿液中出現(xiàn)血液和蛋白質(zhì),并可能導(dǎo)致腎衰竭。您可能會(huì)發(fā)燒、身體疼痛、關(guān)節(jié)和肌肉疼痛,并出現(xiàn)褐色或茶色尿液。

尿路堵塞
如果你無(wú)法小便,這可能意味著尿液被倒流,這會(huì)損害你的腎臟。這會(huì)對(duì)腎臟和身體其他部位造成壓力并導(dǎo)致感染。前列腺肥大、前列腺癌、腎結(jié)石、膀胱癌、尿路血栓和結(jié)腸癌是導(dǎo)致這種情況的一些原因。如果你小便次數(shù)比平時(shí)少很多或多很多,或者尿液中有血,請(qǐng)去看醫(yī)生。

血栓
許多疾病都會(huì)導(dǎo)致血栓,但有一種血液疾病——血栓性血小板減少性紫癜——通常與腎臟問(wèn)題有關(guān)。它會(huì)導(dǎo)致微小血管中形成血栓,也會(huì)影響大腦和心臟。癥狀包括發(fā)燒、鼻子或牙齦出血、腹瀉、胸痛、精神錯(cuò)亂、頭痛、瘀傷和感覺(jué)非常疲倦。如果不及時(shí)治療,病情可能會(huì)很嚴(yán)重,所以如果你有任何這些癥狀,請(qǐng)去看醫(yī)生。

硬皮病
這是一組罕見(jiàn)疾病,會(huì)使您的皮膚和結(jié)締組織變硬變緊。有時(shí)它還會(huì)損害其他器官,如血管和器官。如果它影響到您的腎臟,并且腎臟無(wú)法正常工作,蛋白質(zhì)就會(huì)通過(guò)尿液排出。它還會(huì)導(dǎo)致血壓突然升高,從而導(dǎo)致快速腎衰竭。

多囊腎
這會(huì)導(dǎo)致腎臟內(nèi)長(zhǎng)出囊腫(通常充滿液體的小瘡)。這會(huì)使囊腫比正常大小大得多,并損害腎臟組織。這是由您從父母一方遺傳的問(wèn)題基因引起的。如果不及時(shí)診斷和治療,可能會(huì)導(dǎo)致慢性腎病,并最終導(dǎo)致終末期腎病。

參考資料:
圖片提供者:
- KATERYNA KON/科學(xué)來(lái)源
- AndreyPopov/蓋蒂圖片社
- 卡塔齊娜·比亞拉西維奇/蓋蒂圖片社
- zencreation/蓋蒂圖片社
- 克里斯托夫·伯格施泰特/蓋蒂圖片社
- 法國(guó)國(guó)家科研中心/科學(xué)來(lái)源
- 法國(guó)國(guó)家科研中心/科學(xué)來(lái)源
- iLexx/蓋蒂圖片社
- 卡羅爾沃納/醫(yī)學(xué)圖像
- R.SPENCER PHIPPEN/醫(yī)學(xué)圖像
- SCIEPRO/科學(xué)之源
- SPL/科學(xué)來(lái)源
- PDSN/醫(yī)學(xué)圖像
參考:
免責(zé)說(shuō)明:本文僅用于傳播科普知識(shí),分享行業(yè)觀點(diǎn),不構(gòu)成任何臨床診斷建議!杭吉干細(xì)胞所發(fā)布的信息不能替代醫(yī)生或藥劑師的專業(yè)建議。如有版權(quán)等疑問(wèn),請(qǐng)隨時(shí)聯(lián)系我。
- 美國(guó)腎臟病雜志:“神經(jīng)性厭食癥和腎臟。”
- 美國(guó)腎臟基金會(huì):“多囊腎病”、“腎衰竭/ESRD”、“慢性腎病 (CKD)”、“腎臟疾病”。
- 梅奧診所:“酒精濫用障礙”、“血管炎”、“多發(fā)性骨髓瘤”、“溶血性尿毒癥綜合征 (HUS)”、“急性腎衰竭”。
- 多發(fā)性骨髓瘤研究基金會(huì):“腎功能下降”。
- 美國(guó)國(guó)立衛(wèi)生研究院:“什么是血栓性血小板減少性紫癜?”“高血壓與腎臟疾病”、“糖尿病腎臟疾病”。
- 美國(guó)國(guó)家腎臟基金會(huì):“酒精與您的腎臟”、“狼瘡與腎臟疾病(狼瘡性腎炎)”、“膽固醇與慢性腎臟疾病”、“糖尿病——腎臟疾病的主要風(fēng)險(xiǎn)因素”、“腎小球腎炎”。
- 血栓性血小板減少性紫癜基金會(huì):“TTP 概述”。
- 北卡羅來(lái)納大學(xué)醫(yī)學(xué)院:“ANCA 血管炎。”
掃碼添加微信